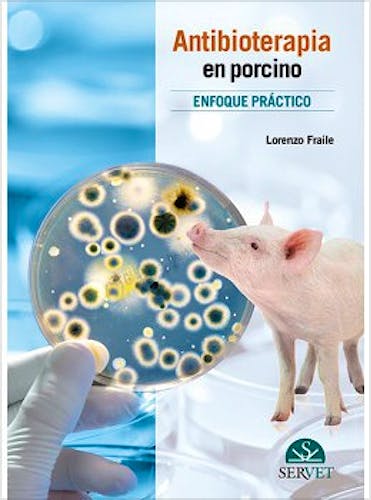

No hay productos en el carrito

Antibioterapia en Porcino. Enfoque Practico
Fraile, L.
1ª Edición Marzo 2016
Español
Tapa dura
168 pags
690 gr
17 x 25 x 2 cm
ISBN 9788416315840
Editorial SERVET DISEÑO Y COMUNICACIÓN
LIBRO IMPRESO
-5%
50,00 €47,50 €IVA incluido
48,08 €45,67 €IVA no incluido
Recíbelo en un plazo de
7 - 10 días
Descripcion
En este libro sobre antibioterapia práctica en la especie porcina, el autor presenta, de forma práctica y desde una perspectiva actualizada, los aspectos más importantes que un veterinario clínico debería tener en cuenta para diseñar tratamientos antimicrobianos adecuados en cerdos. Esta revisión de los conocimientos actuales en farmacología se acompaña de casos clínicos reales resueltos por el autor, siempre bajo la premisa de que el uso prudente de los antibióticos es esencial para prevenir la aparición de resistencias.
© 2025 Axón Librería S.L.
2.149.0